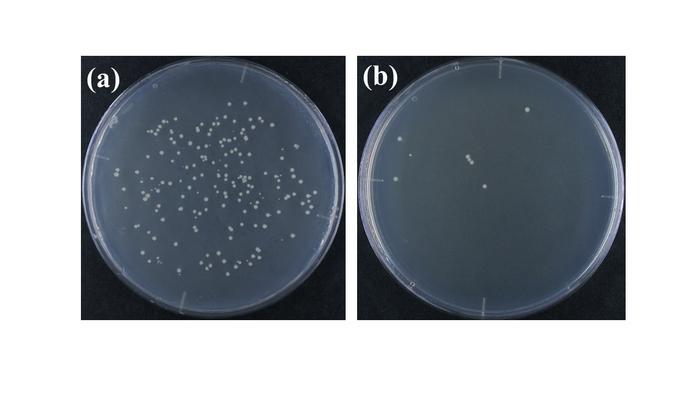

Revealing New Discoveries in X-Ray Sterilization: The Crucial Role of Dose Rate
Revealing New Discoveries in X-Ray Sterilization: The Crucial Role of Dose Rate
In a groundbreaking study poised to redefine the science of radiation sterilization, researchers at Nagoya City University have unveiled astonishing new insights into how X-ray dose rates impact the bactericidal efficiency against Escherichia coli. Contrary to long-standing assumptions that total irradiation dose alone dictates sterilization success, this pioneering research illuminates the complex interplay between dose rate, exposure duration, and bacterial metabolic state—revolutionizing our understanding and practical applications of radiation technology in sterilization and therapy.
Radiation sterilization, a vital tool employed across medical, pharmaceutical, and food industries, relies on high-energy electromagnetic waves to obliterate microbial life by inflicting irreparable damage to DNA and crucial cellular structures. The conventional doctrine held that administering a fixed irradiation dose was the principal determinant of sterilization outcomes, irrespective of how that dose was distributed over time. This paradigm is now challenged by the meticulous experiments led by Professor Matsumoto and Associate Professor Iwata, whose work reveals how profoundly dose rate can modulate bacterial inactivation.
Utilizing Escherichia coli as a robust model organism, the researchers carefully manipulated X-ray irradiation parameters, maintaining a constant total dose of 200 Gray (Gy) while substantially varying the dose rate across two distinct experimental conditions. In nutrient-deprived environments, prolonged exposure at a low dose rate (approximately 15.3 milligray per second [mGy/s]) rendered more effective bacterial destruction than brief but intense irradiation bursts at a high dose rate (147 mGy/s). Specifically, the low-rate regime reduced bacterial counts from 36,000 to a mere 8 after over 13,000 seconds of exposure, corresponding to a striking 99.98% inactivation rate.
Conversely, when bacteria inhabited rich nutrient environments that support vigorous metabolism and replication, the opposite trend emerged. Rapid, high-intensity X-ray exposures outperformed lengthier low-dose treatments by more than an order of magnitude in sterilization efficiency. This finding poignantly demonstrates that the physiological state of bacterial populations dramatically influences their susceptibility to radiation, emphasizing the necessity to tailor sterilization protocols to environmental and biological contexts.
The duality observed between nutrient states hints at complex underlying mechanisms dictating cellular responses to ionizing radiation. In nutrient-poor scenarios, bacteria may enter a dormant or slow-growing phase characterized by altered DNA repair pathways and metabolic quiescence, rendering them more vulnerable to cumulative radiation damage delivered slowly over time. In contrast, actively dividing cells in nutrient-rich media might be more prone to immediate DNA double-strand breaks and oxidative stress caused by intense, concentrated irradiation doses, leading to rapid cell death.
To unravel these intricate effects, the team employed stochastic differential equations, a sophisticated mathematical modeling approach capable of capturing the probabilistic nature of molecular damage and repair dynamics under varying irradiation conditions. This advanced quantitative analysis facilitated an unprecedented mechanistic understanding of radiation-induced bacterial inactivation, bridging experimental observations with predictive theoretical frameworks.
Beyond the microbiological realm, these findings carry profound implications for the broader field of radiation therapy, including cancer treatment. By exploiting the dose-rate dependency and leveraging the distinct metabolic profiles of malignant versus healthy tissues, clinicians may develop irradiation strategies that preferentially target rapidly proliferating cancerous cells while minimizing collateral damage to normal cells. This time-dose reciprocity mechanism paves the way for safer and more effective radiation modalities using X-rays, proton beams, or other ionizing radiation sources.
Moreover, the study challenges the existing sterilization protocols employed for sensitive materials like disposable medical devices, pharmaceuticals, and food products. Optimizing dose rate parameters tailored to specific microbial environments could significantly enhance sterilization efficacy, reduce treatment times, and preserve the integrity of sterilized goods, addressing longstanding logistical and safety concerns.
The rigorous experimental design and interdisciplinary analysis underscore the importance of revisiting classical assumptions within radiobiology. The paradigm shift proposed by the Nagoya City University team highlights the intricate biological and physical interdependencies governing radiation response, urging practitioners and researchers alike to incorporate dose-rate considerations into their frameworks.
In essence, this research charts a transformative path forward, not only deepening scientific knowledge but also informing the engineering of next-generation irradiation systems. Devices capable of dynamically modulating dose rates with precision may become instrumental in diverse applications ranging from hospital sterilization chambers to advanced cancer radiotherapy suites.
As the quest for enhanced sterilization and treatment technologies intensifies, integrating mathematical modeling and experimental biology presents a powerful blueprint. The successful demonstration of time-dose reciprocity in microbial inactivation affirms the untapped potential residing at the intersection of physics, biology, and applied mathematics.
Future research building upon these findings might explore a wider array of microorganisms, different radiation types, and variable environmental conditions to generalize and refine the dose-rate effect. Such efforts could also investigate synergistic combinations with chemical sterilants or radiosensitizers, further expanding the arsenal against microbial contamination and malignancy.
Ultimately, the novel insights derived from this study herald a new era in radiation science—one marked by precision, adaptability, and heightened biological understanding. The implications extend far beyond sterilization, offering promising avenues to safeguard patients, consumers, and ecosystems through scientifically informed radiation applications.
Subject of Research: Not applicable
Article Title: Time-dose reciprocity mechanism for the inactivation of Escherichia coli using X-ray irradiation
News Publication Date: 28-Apr-2025
Web References: http://dx.doi.org/10.1038/s41598-025-96461-1
Image Credits: © Nagoya City University
Keywords: radiation sterilization, dose rate, X-ray irradiation, Escherichia coli, bactericidal effect, sterilization efficiency, stochastic differential equations, radiation therapy, time-dose reciprocity, medical sterilization, microbial inactivation, ionizing radiation
Advanced Multi-Task Motion Coordination in Physically Constrained Quadruped Manipulators Achieves New Breakthrough
Next PostDeep Neural Networks in Stock Trend Prediction: Myth or Reality?
Uncovering the Key Interactions Behind Cell Migration in Brain Cancer







